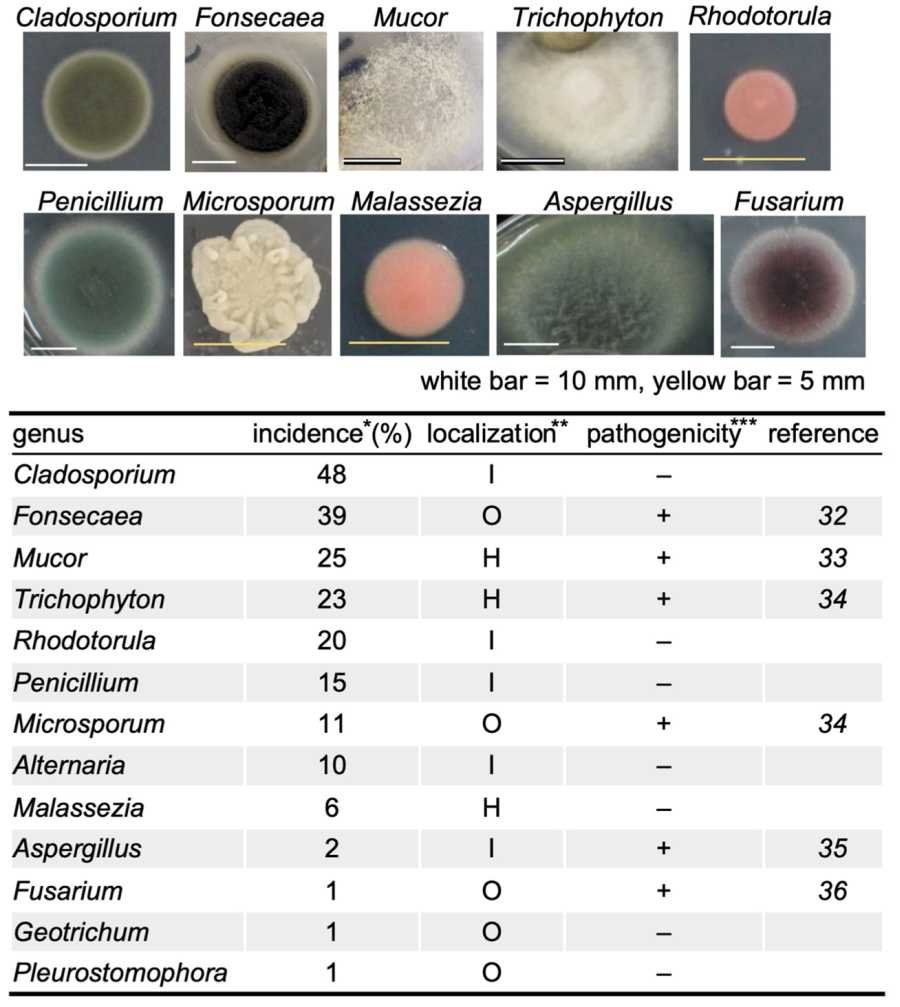

Professors Michael Baker and Siouxsie Wiles are currently going all in on mask wearing.
Baker has likened the unmasked to “murderers” and “drunk drivers” (???).
Prime Minister Ardern is being widely rebuked for a photo op at the Beehive of a very large unmasked group. Her excuse:
“the photographer
made me do it”.
A Japanese report published by Nature on July 18 2022 entitled “Bacterial and fungal isolation from face masks under the COVID-19 pandemic” should raise eyebrows and lower face masks further.
A picture is worth a thousand words, so try Figure 5. These are the organisms found growing on face masks:
Note the pathogenicity column. These are dangerous for humans. The authors say:
“Since masks can be a direct source of infection to the respiratory tract, digestive tract, and skin, it is crucial to maintain their hygiene to prevent bacterial and fungal infections that can exacerbate COVID-19.”
The study found:
“We observed bacterial colonies in 99% of the samples on the face-side and 94% on the outer-side….We found no significant differences in the colony counts among the different mask types [non-woven, polyurethane, and gauze or cloth], regardless of the duration of usage.”
Forget ordinary washing, nothing short of prolonged boiling can get rid of these pathogens. Even frequent mask changes are ineffective, pathogens rapidly reappear, as fabric surfaces provide ideal homes for their colonies.
The authors concluded:
“We propose that immunocompromised people should avoid repeated use of masks to prevent microbial infection.”
Reports indicate that our hospitals are swamped with cases of respiratory illness. Is prolonged mask use exacerbating the situation? Very probably.
mRNA vaccination has been associated with immune deficiency….
Evidence for mask use is at best weak and contradictory. To assess the counter arguments read this. The Japanese report is one more nail in the coffin. The damaging effects on children’s development is also well known.
But if you listened to Michael Baker’s multiple mainstream media interviews (see this for example) over the last week you wouldn’t be aware that there is any doubt on the subject of mask wearing.
He is going full tilt at Ardern to mandate them for school children, no exemptions, and he is getting plenty of sympathetic coverage in MSM. Is she going to give in? You never know.
As we reported yesterday, there are some sad truths here. Many of our experts are falling behind when it comes to reading the latest studies, or if they do read them, dogma ensures they only see what they want to see.
Government funding distorts actions and advice further. Who in New Zealand is going to willingly give up generous government grants and payments in order to tell it how it is?
At this point, New Zealand appears to be facing a science crisis. Some experts might benefit from a break to restudy, recharge, and reassess what works and what doesn’t according to the published science record.






